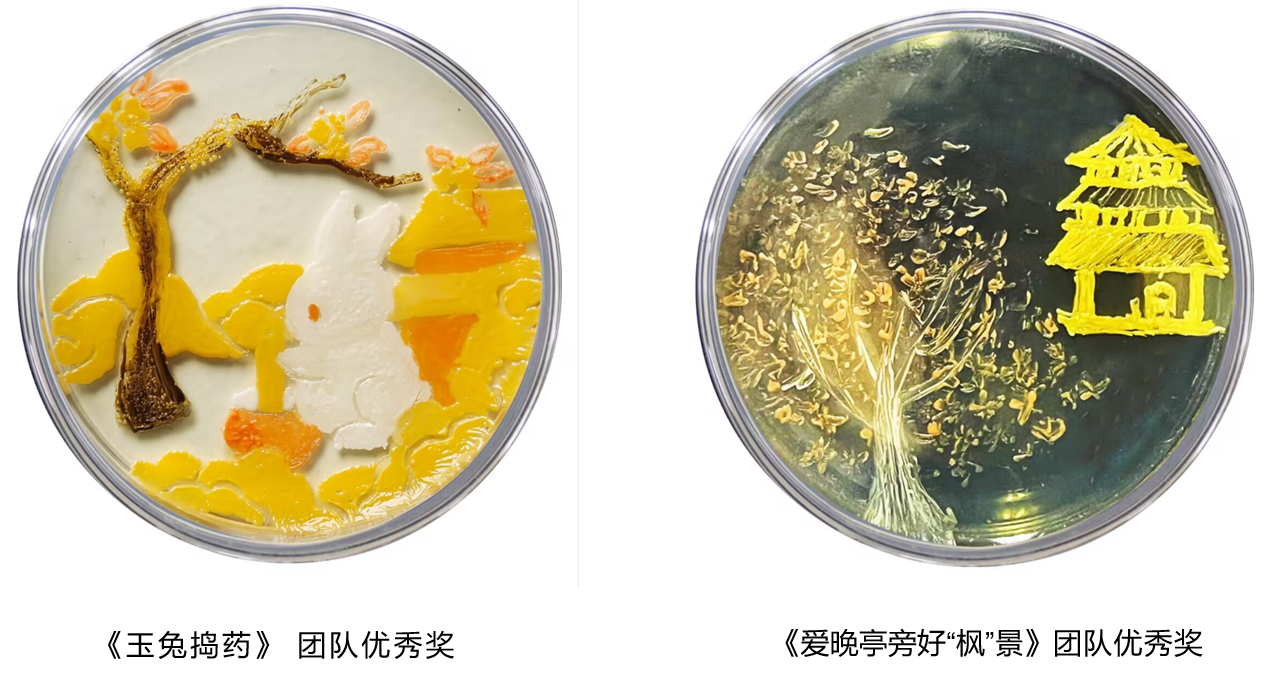

2024年3月5日,由中国轻工业联合会、中国生物发酵产业协会、中国财贸轻纺烟草工会全国委员会共同主办,安琪酵母股份有限公司承办的第一届生物发酵行业微生物培养皿艺术设计大赛颁奖典礼在山东济南举行。Beats365唯一官网入口Beats365唯一官网入口在这次比赛中取得佳绩,获得团体、个人和优秀组织奖共计5项,在2024年的学科竞赛方面实现了“开门红”。由闫达中老师指导,曹佳艳、申梦祺同学的作品《玉兔捣药》获得团队优秀奖;由吴菁老师指导,蔡语悦、罗杭琦、罗莉环同学的作品《爱晚亭旁好“枫”景》获得团队优秀奖;由肖伊娜老师、张美洲老师分别指导的李葵松同学的作品《赤兔呈祥》和张雨轩同学的作品《水袖丹衣》获得个人优秀奖;Beats365唯一官网入口获得最佳组织奖。
该赛事前身为“微生物培养皿艺术大赛”,为公司国B类赛事,由于赛事影响力较大,目前由三个协会共同主办,并且更名为“生物发酵行业微生物培养皿艺术设计大赛”。颁奖典礼举行同时,第二届生物发酵行业微生物培养皿艺术设计大赛启动仪式在山东济南举行,开赛嘉宾有中国生物发酵产业协会理事长于学军,中国生物发酵产业协会副理事长兼秘书长王洁,安琪酵母股份有限公司副总经理吴朝晖,天津科技大学教授王艳萍,Beats365唯一官网入口副教授戴景程,青岛科技大学副教授刘杰,安琪酵母股份有限公司蛋白质营养与调味技术中心副总经理伍业旭,安琪酵母股份有限公司微生物营养事业部总经理杨移志。
近年来,Beats365唯一官网入口高度重视学科竞赛工作,成立了“学科竞赛工作坊”,竞赛获奖数目和级别逐年上升。Beats365唯一官网入口相关负责人表示,此项成绩的取得是Beats365唯一官网入口近年来坚持本科生创新创业教育,依托公司“老员工创新创业中心”和“学科竞赛工作坊”,深入推进“三位一体”创新人才培养模式探索,推动公司本科人才培养质量提升的有力彰显。公司将不断引导员工积极参与科学研究,将所学相关专业知识与实际结合,通过兴趣引领和能力培养,进一步夯实员工专业基础,激发员工学习热情,不断提升人才培养质量。